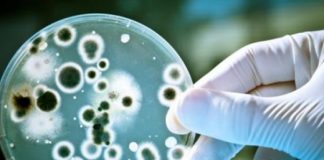
Изолират мъж в Разград със съмнения за антракс антракс

Последвайте ни
Водещи новини
Танкерът „Кайрос“ пое курс към Бургаския залив, теглен от 3 влекача
Очаква се операцията да приключи късно вечерта
Три влекача теглят танкера "Кайрос", който беше заседнал край Ахтопол. Операцията започна около 9:45 ч. в понеделник. Танкерът трябва...
Служители на МВР са задържани при акция на прокуратурата в Ловеч
По-късно ще бъдат оповестени подробности
При проведена акция под ръководството на Окръжна прокуратура-Ловеч са задържани служители на МВР, съобщиха от пресцентъра на прокуратурата. Днес от 13,30...
Сачева на Радев: Влизането в президентската институция е като влизане в най-голямата партийна централа
В следващите часове правителството ще внесе удължителен бюджет
ГЕРБ-СДС няма да участва в съставянето на ново правителство в сегашния парламент
Заместник-председателят на парламентарната група Деница Сачева...
Първите щандове на „Магазин за хората“ ще бъдат официално открити в Куклен днес
Пилотният проект ще стартира в 70 стационарни и един мобилен обект на търговска верига КООП в Пловдивска област
В град Куклен днес официално ще бъдат...
Президентът стартира консултациите с партиите
Днес ще се срещне с представители на ГЕРБ и ПП-ДБ
Президентът Румен Радев започва консултациите за ново правителство в рамките на 51-ото Народно събрание. До това...
Най-четени
Деца и роднини на доносници от ДС са в листите на „Демократична България“
И те са най-активните и най-лансираните за депутати и ни учат на морал
skandal.bg В изборните листи на „Демократична България“ нямало доносници на Държавна сигурност –...
Тошко Йорданов: Къде е моралът на ПП-ДБ да говорят срещу „Ново начало“, при положение...
Няма за какво да се сърдя на Борисов, решението за оставката е взето от трите партии в съвместното управление, каза той Абсурдно е да сме...
И не, Радев, не е „човекът“ на Donald J. Trump- тъкмо обратното
Връщането на ППДБ във властта е крайно несигурно събитие
Борислав Цеков, фейсбук Не следях детайлно обществената ситуация тези дни поради по-важни делови и научни ангажименти. Чак...
Невръстният ентусиаст Наско, с дръзновения поглед на дядо си Наско (Пеканов) – изтъкнат член...
Дядото борец против фашизма, таткото на Пеканов дипломат, но това е изтрито от нета
Мая Сарафова, фейсбук
Невръстния ентусиаст Наско, с дръзновения поглед на дядо си...
Деница Сачева: Свободата на словото не включва правото да сочиш хора и да подканваш...
Дано Gen Z не позволи да бъде водено от хора, които го връщат с бясна скорост назад във времената на Държавна сигурност
Деница Сачева, фейсбук Списъци...